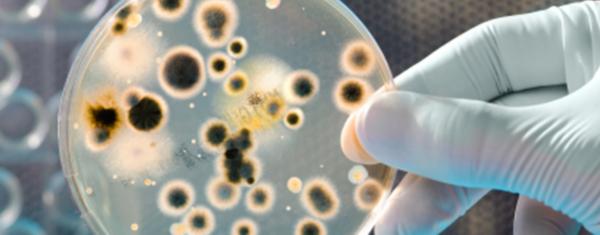
中国青霉素量产方法,青霉素是什么时候量产的

青霉素以及随后各种抗生素对人类的意义就不用多说了,它们不仅让人类的平均寿命增加了15岁,更是在很大程度上消除了人类对疾病的恐惧。在抗生素被发明和使用之前,人们得了病就会想到死,在这之后,人们得了病,就相信医生肯定能治好自己。这便是抗生素给人类带来的最大的意义。
如果现在我问你,谁发现了青霉素?大部分人会说是英国的医生弗莱明。如果我再问,他是如何发现青霉素的?大部分人会说,那是一个偶然的发现。有一次弗莱明发现他培养细菌(葡萄球菌)的培养皿里面长了霉,霉菌周围的细菌似乎被杀死了,然后他便用显微镜观察,证实了这一点,从此他发现了青霉素。

为什么大家会有这样一致的看法呢?因为我们的教科书里就是这么讲的。当然教科书在最后还要教育大家,灵机一动的发明或发现需要有准备的头脑。然后我们大部分人就喝下这碗鸡汤了。接下来两个问题就随之而来了。
首先,弗莱明是受了谁的启发?
事实上,弗莱明的想法来自于德国著名的医生科赫,科赫被誉为“细菌学之父”,他认定感染的病源是细菌,要治疗感染引起的疾病,就要寻找能够从根本上将细菌杀死的药物。

因此,如果我们认定完成从0到1发现的人是弗莱明,科赫要是还活着的话,他可以去争辩说,弗莱明是受了我的理论的启发。
当然,有人会争辩,科赫没有发现青霉可以杀死细菌这件事,因此不算数。那我要告诉你的是,其实弗莱明也不是第一个发现青霉可以杀菌这个现象的人。早在中国唐朝的时候,裁缝们就知道如果划破了手,把长了绿毛的浆糊涂在伤口上,能够帮助伤口愈合。
这其实就是绿毛上的青霉素起了杀菌的作用。只不过,唐代的裁缝们不懂科赫那一大堆的理论,他们解释不了其中的原因,因此这种土办法也没有得到推广。更关键的是,光靠绿毛上那点霉菌其实也治不了大的伤病,那种能杀菌的天然物根本算不上药。

寻找第一个发明人常常没有意义,因为根本找不清,永远能够往前追溯。在人类的技术发展历史上,有无数的从0到1的发明,但是绝大部分走不完到N的过程,因此都没有产生什么效果,最后就被大家遗忘了。
不仅唐朝裁缝没有发明青霉素这种药,实际上弗莱明也没有。
为什么弗莱明没有完成从0到N的全过程呢?
首先,弗莱明的知识结构不完整,他是一个著名的医生,但是他不懂化学,也不懂制药学,因此他无法搞清楚青霉素的有效成分,也无法从带有青霉菌的果汁中提炼出药物。

此外,还有两个客观原因。
第一,当时药物提纯水平很差。弗莱明培养的青霉菌,每一升培养液只能产生两个单位的青霉素。按照今天门诊肌肉注射青霉素一天60万~80万单位的用量估算,这需要将一个25米的短道游泳池的水都灌到人体中。此外,因为浓度太低,用青霉素做实验时灵时不灵,这是今天科学研究的大忌。
第二个客观原因,也是很关键的,就是弗莱明没有经费支持。因此,弗莱明在发现青霉素后的10年里,尽管他还在研究青霉素,但是没有什么进展。

那么,青霉素到底是怎么从天然物变成药物,真正实现了从0到N的全过程呢?一个叫弗洛里的牛津大学教授起了关键的作用。
1938年,就在弗莱明打算放弃对青霉素的研究时,澳大利亚药物学家弗洛里和他的同事、生物化学家钱恩注意到了弗莱明的那篇论文,于是从弗莱明那里要来了霉菌的母株,开始研究青霉素。
和弗莱明不同的是,弗洛里精通药理,更重要的是,他有非凡的组织才能,而且他手下还有一批能干的科学家,除了钱恩,还有后来对抗生素做出巨大贡献的亚伯拉罕和希特利,是他们联合美国的科学家,将青霉素从天然物变成了药。他们前后解决了八大难题。
1.钱恩和亚伯拉罕首先从青霉菌中分离和浓缩出了它的有效成分——青霉素。
2.为了得到足够的青霉素做实验,弗洛里以超低薪水雇用了很多当地的女孩,将牛津大学里能找到的各种瓶瓶罐罐都用上了,培养青霉素。大家说他把牛津大学变成了霉菌工厂。
3.希特利研制出一种青霉素的水溶液,并且调整了药液的酸碱度,这才使得青霉素能够用于动物和人体。
4.1940年夏天,弗洛里和钱恩用了50只被细菌感染的小白鼠完成了药物的对比实验,25只注射了青霉素的小白鼠都活了,25只没有注射的死了,证明了青霉素的药效,而且显示出它的毒性不大。

但是,用这种常规方法获得的青霉素很少,甚至不够救治一个细菌感染的病人。于是弗洛里开始寻求工业界,即药厂的帮助。他先联系了英国的药厂,但所有的力量合在一起也不足以解决问题。
于是,弗洛里和希特利去美国寻求帮助,钱恩和亚伯拉罕留在英国继续搞研究。这次合作的经费,是洛克菲勒基金会出的。弗洛里等人和美国人一道,又解决了剩下的四个难题:
5.改进培养液。
用玉米浆代替原来的蔗糖液做培养液,可以将产量提高20倍。

6.寻找新的菌种。
世界上的霉菌有很多种,有的容易产生青霉素,有的则根本没有。为了寻找新的菌种,希特利将实验室的人都派了出去。结果一位叫玛丽∙亨特的实验人员在水果摊上找到了一种长了毛的哈密瓜,发现上面的黄绿色霉菌已经长到了深层,于是就把它带了回来。
弗洛里检查了哈密瓜上的绿毛,发现这是能够提炼青霉素的黄绿霉菌。采用了新的菌种,再加上后来的射线照射处理,使得青霉素的产量又提高了1000倍。

今天人们通常讲在发明青霉素的过程中有两次偶然的运气,第一次是弗莱明的那一次,第二次就是这个玛丽带回的绿毛哈密瓜。
7.让青霉素从实验室到量产。
能够从实验室得到青霉素,不等于工厂里能批量生产出来,这件事需要很多制药公司共同努力。这时候,弗洛里的组织才能再一次显现出来。长话短说,最终他克服了很多困难,说服了默克(Merck)、辉瑞、施贵宝和礼来(Lilly)四家著名制药公司共同研制和生产青霉素。

8.实现青霉素大规模的量产。
即便在工厂能生产青霉素后,产量依然很少。于是美国几十家药厂上千名工程师通力合作,使得青霉菌的浓度又增长了近百倍,才使得工厂能够大量生产这种药品。青霉素项目是美国在二战期间仅次于曼哈顿计划的第二重要的项目,得到了从政府到企业界巨大的支持。
到了诺曼底登陆时,每一位盟军伤员都能使用上青霉素。由于有了青霉素,英军虽然在第二次世界大战中参战的人数和第一次世界大战相当,但是死亡人数下降了很多。至此青霉素的研制才算告一段落,但是依然没有结束。

二战时留在英国的亚伯拉罕在1943年发现了青霉素中的有效成分青霉烷,这就让药用的青霉素可以保留有效的成分而滤除各种可能有害的无用杂质。
1945年,英国著名女科学家多萝西∙霍奇金通过X射线衍射得到了青霉烷的分子结构,并因此获得了诺贝尔奖,这使得美国麻省理工学院的希恩得以在1957年成功地合成了青霉素,从此生产青霉素不再需要培养霉菌了。同年,弗洛里、钱恩和弗莱明因青霉素相关工作获得诺贝尔生理学或医学奖。